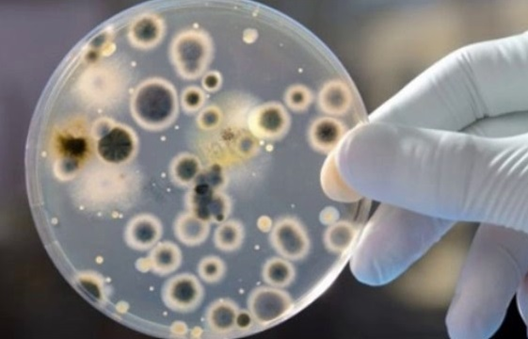

Ki̇f və nəmlə mübari̇zə
Kif göbələyi tərkibində toksik maddələrin bol olduğu canlı orqanizmdir. Onun tərkibində olan toksik maddələr insan orqanizminə ciddi ziyan vurur, xüsusilə də qaraciyəri zədələyir.
Tədqiqatlar göstərir ki, uzun müddət kif göbələyinə məruz qalan insanlarda qaraciyər xərçəngi təhlükəsi var.
Tədqiqatlar göstərir ki, uzun müddət kif göbələyinə məruz qalan insanlarda qaraciyər xərçəngi təhlükəsi var.
KİF VƏ NƏMİN YARATDIĞI FƏSADLAR:
1.Yaşam komfortunun pozulması (vizual, estetik görünüş)
- Xoşagəlməz qoxu (bəzən onu zirzəmi qoxusu, yaxud durğun su qoxusu adlandırırlar)
- Divarlarda qara və yaxud boz-yaşıl göbələk ləkələri

2. Xəstəliklərin təzahürü
- Dermatoz, mikoz, göbələk və s. simptomların allergik təzahürü
- Böyük ehtimalla qaraciyər xərçənginin yaranması riski
- Tənəffüs sistemi və selikli qişada xəstəliklərin yaranması (astma, pnevmoniya, sinuzit, haymorit və s.)
«Dost usta» şirkəti sizə xüsusi avadanlıqlar və kimyəvi məhlullarla evinizdə və obyektlərinizdə nəmliyin yaratdığı kifin (göbələk xəstəliyinin) aradan qaldırılmasını və təkrar yaranmasının qarşısının alınması xidmətini təqdim edir.
XİDMƏTƏ DAXİLDİR:
XİDMƏTƏ DAXİLDİR:
- Dezinfeksiya avadanlığı ilə Ozon O³ qazından istifadə etməklə kif göbələyinin məhv edilməsi
- Kimyəvi məhlullarla kifin yaratdığı ləkələrin aradan qaldırılması və təkrar yaranmasının qarşısının alınması alır
- Nəmliyin mənbəyinin təyin edilməsi və izolyasiya işlərinin aparılması (sifariş olunarsa)


«Dost usta» şirkəti tərəfindən istifadə olunan son texnologiyaya uyğun, müasir Ozon O³ avadanlığı sadəcə göbələk bakteriyalarını deyil, həmçinin orqanizmə zərərli olan bir çox virus və parazitləri məhv edir. Bununla yanaşı, havada olan pis qoxu molekullarını məhv edərək evinizin havasının təravətli olmasını təmin edir.
Şimşəkli, yağışlı havadan sonra və ya şəlalənin ətəyində durduqda sərin təravətin qeyri-adi qoxusunu xatırlayırsınızmı? Kiçik konsentrasiyalarda ozon qazının qoxusu o cür olur, təbiətdə havanı təmiz və təravətli edən məhz bu qazdır.
Şimşəkli, yağışlı havadan sonra və ya şəlalənin ətəyində durduqda sərin təravətin qeyri-adi qoxusunu xatırlayırsınızmı? Kiçik konsentrasiyalarda ozon qazının qoxusu o cür olur, təbiətdə havanı təmiz və təravətli edən məhz bu qazdır.
